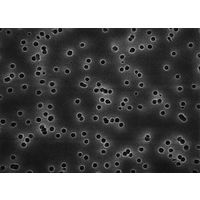

「hp pc」の人気商品一覧 | 安い商品を通販サイトから探す
2,404件 201〜240件を表示- 価格の安い順
- 価格の高い順
- 検索条件:
- その他の作業用品
- 本ページでは掲載するECサイトやメーカー等から購入実績などに基づいて手数料を受領しています。
その他の作業用品
チタン合金などの切りくずが切れにくい被削材に。 無人化生産向けに。 ■仕様 コロターンHP ●コロターンHP 【入数】 1 A32TPCLNR12HP...

その他の作業用品
して使用します。 購入しやすい少量パックです。 ■用途 機械部品の抜け止めや位置決めに。 ■仕様 HP C型止輪 穴 Dセット ■材質 ステンレス(SUS304) JAN:4962123866016 仕様...
その他の作業用品
機械やワークへの絡みつきを防止します。 ■仕様 センサクホルダHP ●センサクホルダHP 【入数】 1 C5PSKNR2211012HP...

その他の作業用品
【送料無料!最短当日お届け】 オフィス用品のアスクル(askul)へようこそ。こちらは法人様向け通販のアスクル・インターネットショップになります。当日または翌日以降お届け、法人は2000円(税込)以上配送料当社負担!※配送料・お届けは...
その他の作業用品
【送料無料!最短当日お届け】 オフィス用品のアスクル(askul)へようこそ。こちらは法人様向け通販のアスクル・インターネットショップになります。当日または翌日以降お届け、法人は2000円(税込)以上配送料当社負担!※配送料・お届けは...

その他の作業用品
しっかりフィットする設計: これらのスナップオンプラグは、5mm から 50mm までの穴にぴったりフィットし、さまざまな用途で安定した保持を保証します。 耐久性のあるナイロン素材: 丈夫なナイロン製のキャップは、簡単にひび割れたり変...

その他の作業用品
しっかりフィットする設計: これらのスナップオンプラグは、5mm から 50mm までの穴にぴったりフィットし、さまざまな用途で安定した保持を保証します。 耐久性のあるナイロン素材: 丈夫なナイロン製のキャップは、簡単にひび割れたり変...

その他の作業用品
コロマントキャプトT-MaxP用HPカッティングヘッド ●コロマントキャプトT-MaxP用HPカッティングヘッド 【入数】 1 C8PCLNR5508016HP...

その他の作業用品
D5m:32 ●D ●サンドビック コロターンSL T−Max P用HPカッティングヘッド 【入数】 1 SLPCLNL3212HP...

その他の作業用品
【送料無料!最短当日お届け】 オフィス用品のアスクル(askul)へようこそ。こちらは法人様向け通販のアスクル・インターネットショップになります。当日または翌日以降お届け、法人は2000円(税込)以上配送料当社負担!※配送料・お届けは...

その他の作業用品
【特長】 ●2本爪油圧式プーリ抜きです。 ●サビ、焼付などのギヤ・プーリなどの引き抜きが油圧パワーにより容易です。 【用途】 ●油圧の力で引き抜き。
この商品で絞り込む

その他の作業用品
【送料無料!最短当日お届け】 オフィス用品のアスクル(askul)へようこそ。こちらは法人様向け通販のアスクル・インターネットショップになります。当日または翌日以降お届け、法人は2000円(税込)以上配送料当社負担!※配送料・お届けは...

その他の作業用品
コロマントキャプトT-MaxP用HPカッティングヘッド ●コロマントキャプトT-MaxP用HPカッティングヘッド 【入数】 1 C6PCRNL3506519HP...

その他の作業用品
機械やワークへの絡みつきを防止します。 ■仕様 センサクホルダHP ●センサクホルダHP 【入数】 1 C5PWLNR2211008HP...

その他の作業用品
商品画像はイメージ画像です。実際とは異なる場合がございます。 ■仕様 センサクホルダHP ●センサクホルダHP 【入数】 1 C6PDUNL4506515HP

その他の作業用品
しっかりフィットする設計: これらのスナップオンプラグは、5mm から 50mm までの穴にぴったりフィットし、さまざまな用途で安定した保持を保証します。 耐久性のあるナイロン素材: 丈夫なナイロン製のキャップは、簡単にひび割れたり変...

その他の作業用品
機械やワークへの絡みつきを防止します。 ■仕様 センサクホルダHP ●センサクホルダHP 【入数】 1 C4PSKNL2211012HP...

その他の作業用品
台車のハンドルに取り付けて、工具や文房具などを収納できる収納ポケット。トリガータイプのバーコードリーダーの収納にも対応する大型サイズ。●台車のハンドルに取り付けできる収納ポケットです。●面ファスナーで簡単に取り付けで

その他の作業用品
【送料無料!最短当日お届け】 オフィス用品のアスクル(askul)へようこそ。こちらは法人様向け通販のアスクル・インターネットショップになります。当日または翌日以降お届け、法人は2000円(税込)以上配送料当社負担!※配送料・お届けは...

その他の作業用品
【送料無料!最短当日お届け】 オフィス用品のアスクル(askul)へようこそ。こちらは法人様向け通販のアスクル・インターネットショップになります。当日または翌日以降お届け、法人は2000円(税込)以上配送料当社負担!※配送料・お届けは...

その他の作業用品
機械やワークへの絡みつきを防止します。 ■仕様 センサクホルダHP ●センサクホルダHP 【入数】 1 C4PDUNR2708015HP...

その他の作業用品
コロマントキャプトT-MaxP用HPカッティングヘッド ●コロマントキャプトT-MaxP用HPカッティングヘッド 【入数】 1 C8PCLNR5508019HP...

その他の作業用品
コロマントキャプトT-MaxP用HPカッティングヘッド ●コロマントキャプトT-MaxP用HPカッティングヘッド 【入数】 1 C8PCLNL5508012HP...

その他の作業用品
機械やワークへの絡みつきを防止します。 ■仕様 センサクホルダHP ●センサクホルダHP 【入数】 1 C6PDUNL1710011HP...

その他の作業用品
【送料無料!最短当日お届け】 オフィス用品のアスクル(askul)へようこそ。こちらは法人様向け通販のアスクル・インターネットショップになります。当日または翌日以降お届け、法人は2000円(税込)以上配送料当社負担!※配送料・お届けは...

その他の作業用品
サンドビック コロターンHP ●CZCMS:C6 ●DMIN:40 ●DCON:63 ●WF:22 ●LF:120 ●LU:94 ●BD:32 ● ●サンドビック コロターンHP 【入数】 1 C...

その他の作業用品
しっかりフィットする設計: これらのスナップオンプラグは、5mm から 50mm までの穴にぴったりフィットし、さまざまな用途で安定した保持を保証します。 耐久性のあるナイロン素材: 丈夫なナイロン製のキャップは、簡単にひび割れたり変...

その他の作業用品
商品画像はイメージ画像です。実際とは異なる場合がございます。 ■仕様 センサクホルダHP ●センサクホルダHP 【入数】 1 C8PDUNR5508015HP

その他の作業用品
機械やワークへの絡みつきを防止します。 ■仕様 センサクホルダHP ●センサクホルダHP 【入数】 1 C6PCLNR2211012HP...

その他の作業用品
メーカー:スガツネ工業 品番:MDH-PC192 ブラケットとパイプを自由に組み合わせできるハンドルです。
この商品で絞り込む

その他の作業用品
台車のハンドルに取り付けて、バーコードリーダーやスマートフォン、工具や文房具などを収納できる収納ポケット。●台車のハンドルに取り付けできる収納ポケットです。●面ファスナーで簡単に取り付けでき、台車のハンドルスペースを

その他の作業用品
しっかりフィットする設計: これらのスナップオンプラグは、5mm から 50mm までの穴にぴったりフィットし、さまざまな用途で安定した保持を保証します。 耐久性のあるナイロン素材: 丈夫なナイロン製のキャップは、簡単にひび割れたり変...

その他の作業用品
商品画像はイメージ画像です。実際とは異なる場合がございます。 ■仕様 センサクホルダHP ●センサクホルダHP 【入数】 1 C5PDJNL3506011HP

その他の作業用品
(HPHST) 作業手袋P 1001 PROパソコン取付修理静電気防止手袋、高抵抗炭素繊維手袋 (ブラック( 12 副), S) ?静電気防止手袋:プルクローズ。作業手袋を外さずにタッチパネル携帯電話やデバイスを操作する。緻密な炭素繊...

その他の作業用品
商品画像はイメージ画像です。実際とは異なる場合がございます。 ■特徴 高圧クーラント対応の外径旋削ホルダです。 クーラントで刃先を直接冷やすため、切削速度の向上、チップ寿命の延長が図れます。 切りくずを細かく分断し、機械やワークへの絡...

その他の作業用品
商品画像はイメージ画像です。実際とは異なる場合がございます。 ■特徴 高圧クーラント対応の外径旋削ホルダです。 クーラントで刃先を直接冷やすため、切削速度の向上、チップ寿命の延長が図れます。 切りくずを細かく分断し、機械やワークへの絡...

その他の作業用品
サンドビック コロターンHP ●CZCMS:C5 ●DMIN:32 ●DCON:50 ●WF:17 ●LF:90 ●LU:67 ●BD:25 ●C ●サンドビック コロターンHP 【入数】 1 C...

その他の作業用品
しっかりフィットする設計: これらのスナップオンプラグは、5mm から 50mm までの穴にぴったりフィットし、さまざまな用途で安定した保持を保証します。 耐久性のあるナイロン素材: 丈夫なナイロン製のキャップは、簡単にひび割れたり変...
この商品で絞り込む

その他の作業用品
機械やワークへの絡みつきを防止します。 ■仕様 センサクホルダHP ●センサクホルダHP 【入数】 1 C6PSKNR3517515HP...
その他の作業用品カテゴリで検索されているキーワード:
お探しの商品はみつかりましたか?
検索条件の変更
ご利用前にお読み下さい
- ※ ご購入の前には必ずショップで最新情報をご確認下さい
- ※ 「掲載情報のご利用にあたって」を必ずご確認ください
- ※ 掲載している価格やスペック・付属品・画像など全ての情報は、万全の保証をいたしかねます。あらかじめご了承ください。
- ※ 各ショップの価格や在庫状況は常に変動しています。購入を検討する場合は、最新の情報を必ずご確認下さい。
- ※ ご購入の前には必ずショップのWebサイトで価格・利用規定等をご確認下さい。
- ※ 掲載しているスペック情報は万全な保証をいたしかねます。実際に購入を検討する場合は、必ず各メーカーへご確認ください。
- ※ ご購入の前にネット通販の注意点をご一読ください。
- ※ 本ページでは掲載するECサイトやメーカー等から購入実績などに基づいて手数料を受領しています。
- hp pc
- DIY・工具
- 作業用品
- その他の作業用品の通販情報・価格比較
- 価格.com
© Kakaku.com, Inc. All Rights Reserved. 無断転載禁止